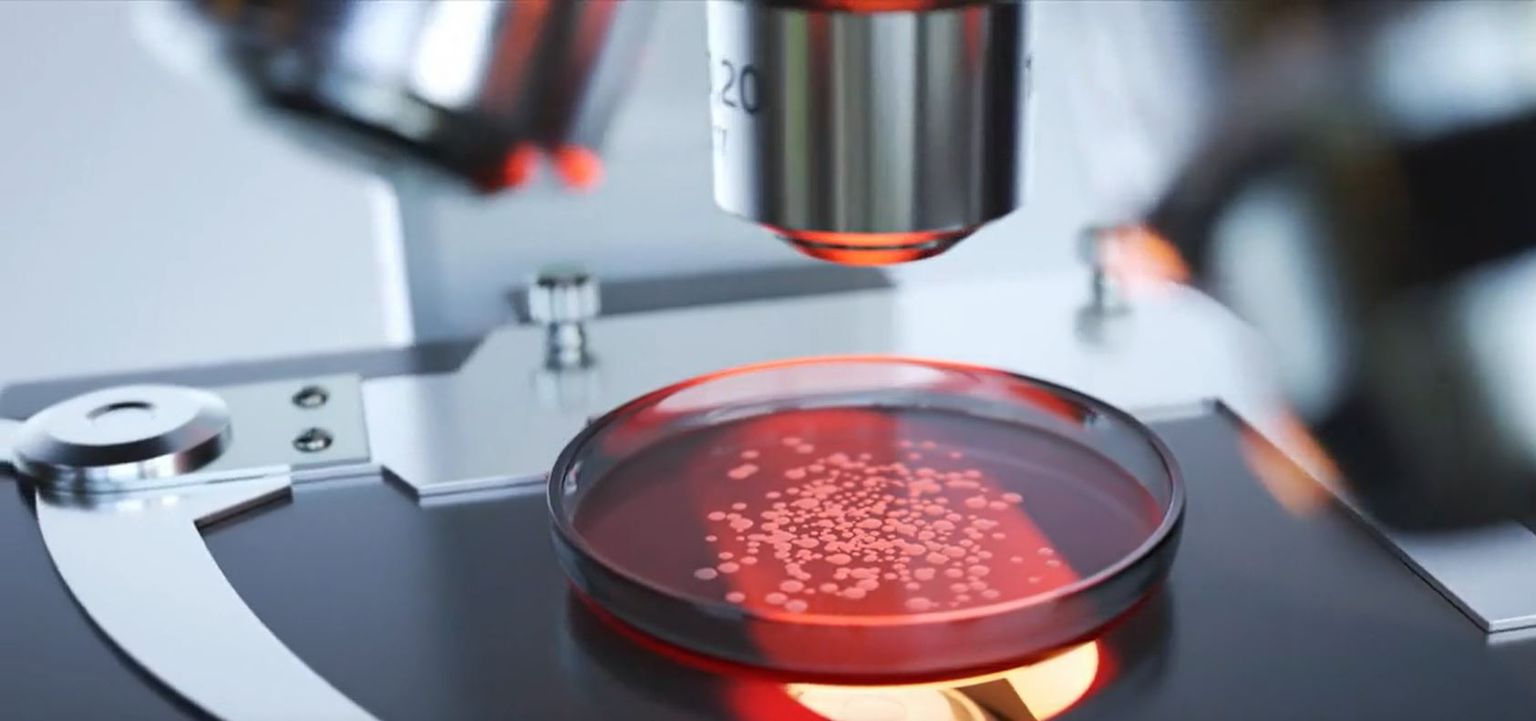

-
 Krunoslav Capak Foto: DNEVNIK.hr
Krunoslav Capak Foto: DNEVNIK.hr -
 Zaraza jednostaničnim parazitom - 5 Foto: DNEVNIK.hr
Zaraza jednostaničnim parazitom - 5 Foto: DNEVNIK.hr -
 Zaraza jednostaničnim parazitom - 4 Foto: DNEVNIK.hr
Zaraza jednostaničnim parazitom - 4 Foto: DNEVNIK.hr -
Zaraza jednostaničnim parazitom - 3 Foto: DNEVNIK.hr
Zaraza jednostaničnim parazitom - 3 Foto: DNEVNIK.hr -
 Zaraza jednostaničnim parazitom - 2 Foto: DNEVNIK.hr
Zaraza jednostaničnim parazitom - 2 Foto: DNEVNIK.hr -
 Ivan Vidos, tvrtka za održavanje i gradnju bazena Foto: DNEVNIK.hr
Ivan Vidos, tvrtka za održavanje i gradnju bazena Foto: DNEVNIK.hr -
 Jasna Valić, epidemiologinja Foto: DNEVNIK.hr
Jasna Valić, epidemiologinja Foto: DNEVNIK.hr -
 Krunoslav Capak, ravnatelj HZJZ Foto: DNEVNIK.hr
Krunoslav Capak, ravnatelj HZJZ Foto: DNEVNIK.hr -
 Krunoslav Capak, HZJZ - 1 Foto: DNEVNIK.hr
Krunoslav Capak, HZJZ - 1 Foto: DNEVNIK.hr -
 Zaraza jednostaničnim parazitom - 1 Foto: DNEVNIK.hr
Zaraza jednostaničnim parazitom - 1 Foto: DNEVNIK.hr -
Pogledaj i ovo





pozivaju Vladu za stol
Uputili hitan poziv Vladi zbog novih nameta, oglasio se ministar: "Svi razgovori će biti obavljeni"





kritizirao ju premijer
Napetosti u koaliciji zbog DP-ove Deklaracije: "Nije najpametnije par mjeseci prije izbora zadirati u osjetljive teme"




složem zahvat
U Sisku predani ključevi najveće zgrade obnovljene od potresa. Ministar: "Evo dokad planiramo sve završiti"

